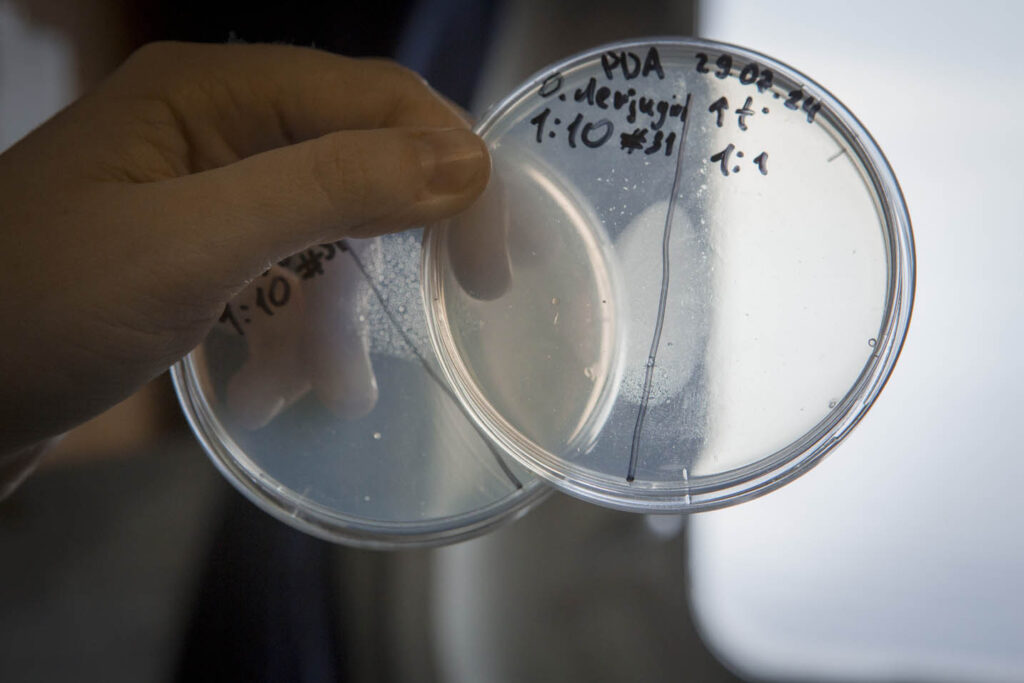

В жёлобе Воронина — пасмурная погода, частые туманы. Температура колебалась между -1,3 до 5,3 °С, у поверхности воды в различных точках — от 0 до 3,4 °С. Максимальная глубина станции на полигоне составила 287 метров. Самые северные измерения на полигоне были выполнены на 80,25° северной широты.
Мы сидим в гидрофизической лаборатории и разглядываем экран компьютера с картой выполненных станций. Кажется, что все предыдущие дни мы ходили кругами. Скорее даже странными зигзагами.

Жёлоб Воронина расположен на северо-восточной окраине Карского моря. Он получил своё название в честь одного из известнейших советских арктических капитанов, участника множества экспедиций, в частности, челюскинской эпопеи. До сих пор этому району уделялось мало внимания, и его роль в трансформации атлантических вод была непонятна.
«Это одна из наших задач в рейсе — изучение водообмена между глубоководными желобами в Карском море, а именно определение возможности затока атлантических вод из жёлоба Святой Анны в жёлоб Воронина, — рассказывает Александр Осадчиев, начальник отряда крупномасштабной гидрофизики. — Карское море — достаточно близкое к нам, но из-за сложной ледовой обстановки и донного рельефа изучено недостаточно, даже хорошей карты течений нет. А мы её потихоньку уточняем, наши измерения впервые показали существование периодического затока тёплых и солёных атлантических вод из жёлоба Святой Анны в Новоземельский жёлоб и жёлоб Воронина Карского моря. Характеристики этих вод сильно отличаются от местных, поэтому также могут сильно повлиять на развитие планктона и более крупных животных».

На карте точки наших недавних остановок образуют крест. Это из-за измерений мезомасштабного вихря, который наши физики засекли спутниковым снимкам. Они вычислили скорость его перемещения и мы скорректировали маршрут так, чтобы собрать побольше данных. «Есть крупные течения, определяющие условия в океане на больших масштабах пространства и времени, — замечает начальник отряда Алексей Зимин, — а есть маленькие вредные вихри — неучтённый перенос тепла! Они могут, например, ускорить таяние ледяного покрова».
Не до отдыха и биологам, каждый спешит отловить и обработать свои образцы. «Мы изучаем бактерии, которые живут на различных морских организмах, — объясняет Дарья Трошина. — Они конкурируют друг с другом и выделяют антибиотики. Многие опасные для человека бактерии могут сформировать устойчивость к уже открытым антибиотикам, что скажется на эффективности лекарств. А здесь может оказаться что-то новое!»
А геохимиков в это время среди нас становится больше: Дарья Шадрина на прошедшей PowerPoint-вечеринке настолько живо описала свою работу, что всё новые и новые люди заходят в лабораторию на корме в свободное от своих вахт время, чтобы поучаствовать в разделении колонок донных отложений. «В одной из колонок я обнаружила микроконкреции — маленькие образования из комплексных соединений железа и марганца. Они хорошо присоединяют к себе редкоземельные элементы из воды, а без них не обойдётся никакая электроника, — рассказывает Даша. — Я очень рада, теперь у себя в лаборатории я смогу заниматься не только конкрециями из Бразильской котловины, но и арктическими!».

«Девять месяцев дрейфовал П.П. Ширшов под руководством Папанина, и сделали они 38 станций» — вспомнил на одной из лекций Алексей Зимин, руководитель отряда мезомасштабной гидрофизики. «Каждый из нас ведёт свои исследования, но все мы стоим на плечах научных гигантов и их прежних открытий», — добавляет биолог Илья Манухов. Под рассказы о прошлом и настоящем океанологии мы начинаем переход из Карского моря в море Лаптевых. Это экватор нашей экспедиции, и за кормой у нас уже более 100 станций.
Авторы: Цедрик Софья, Боровкова Кристина
Фото: Ольга Мерзлякова
